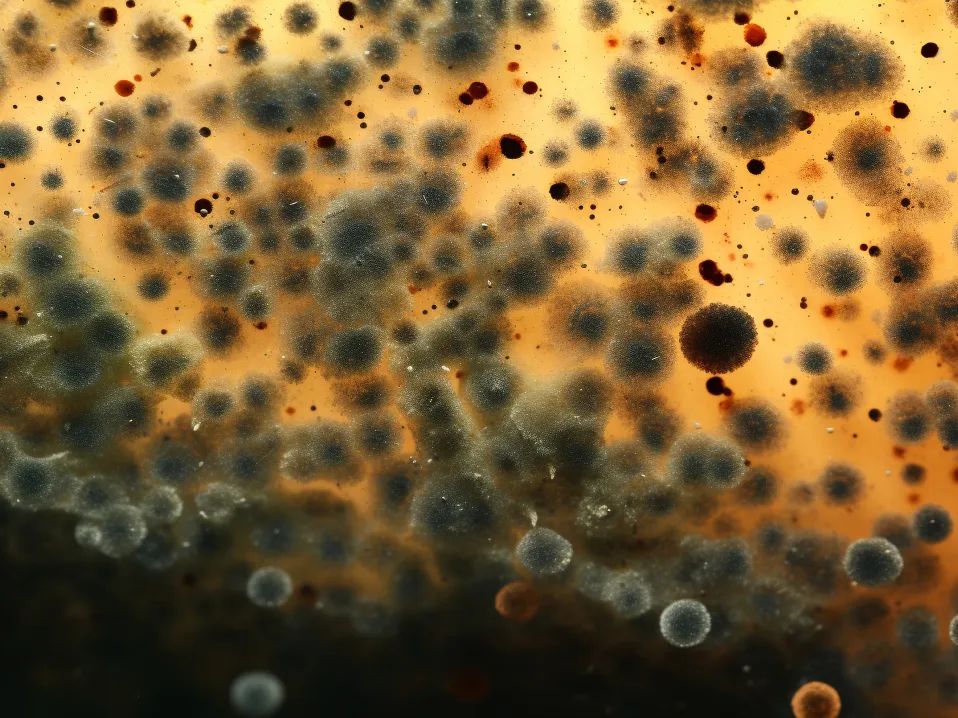
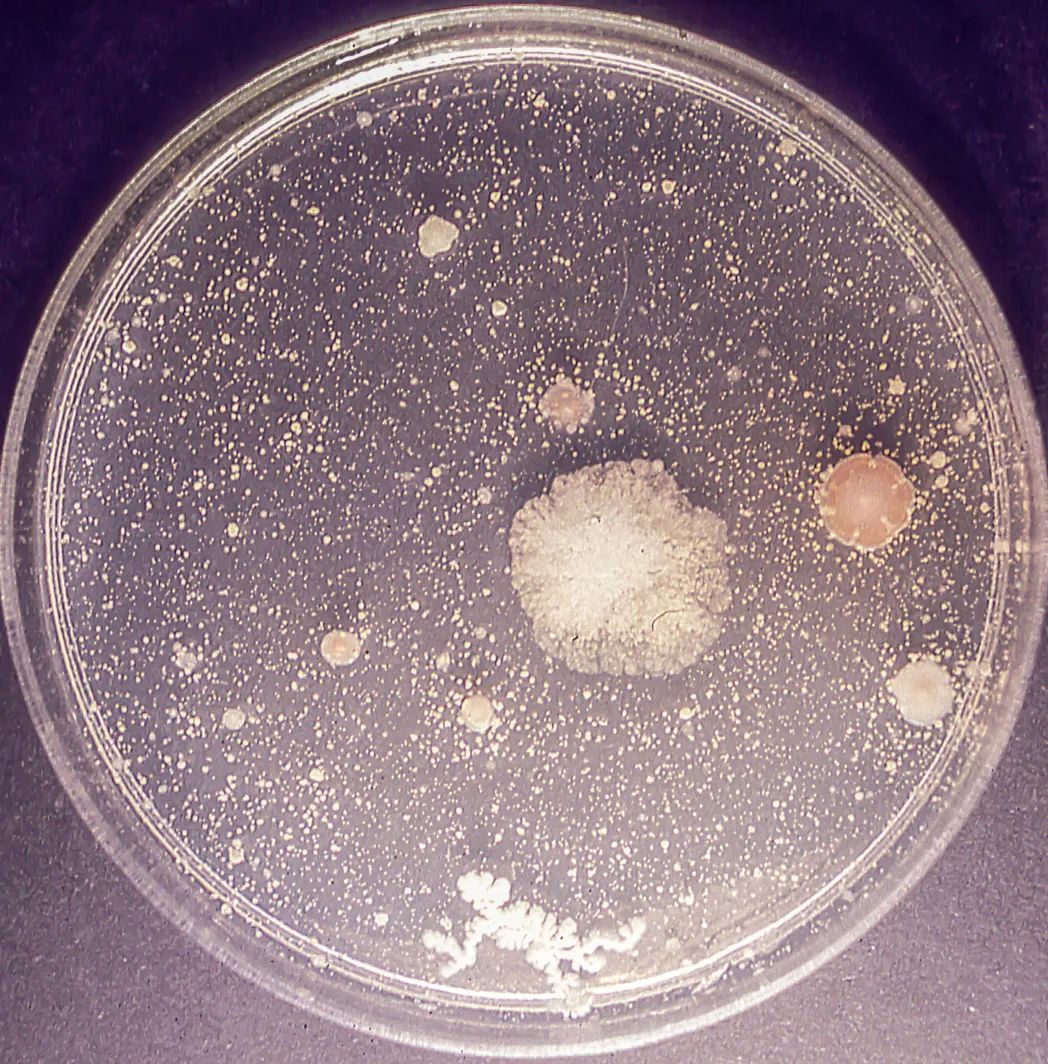
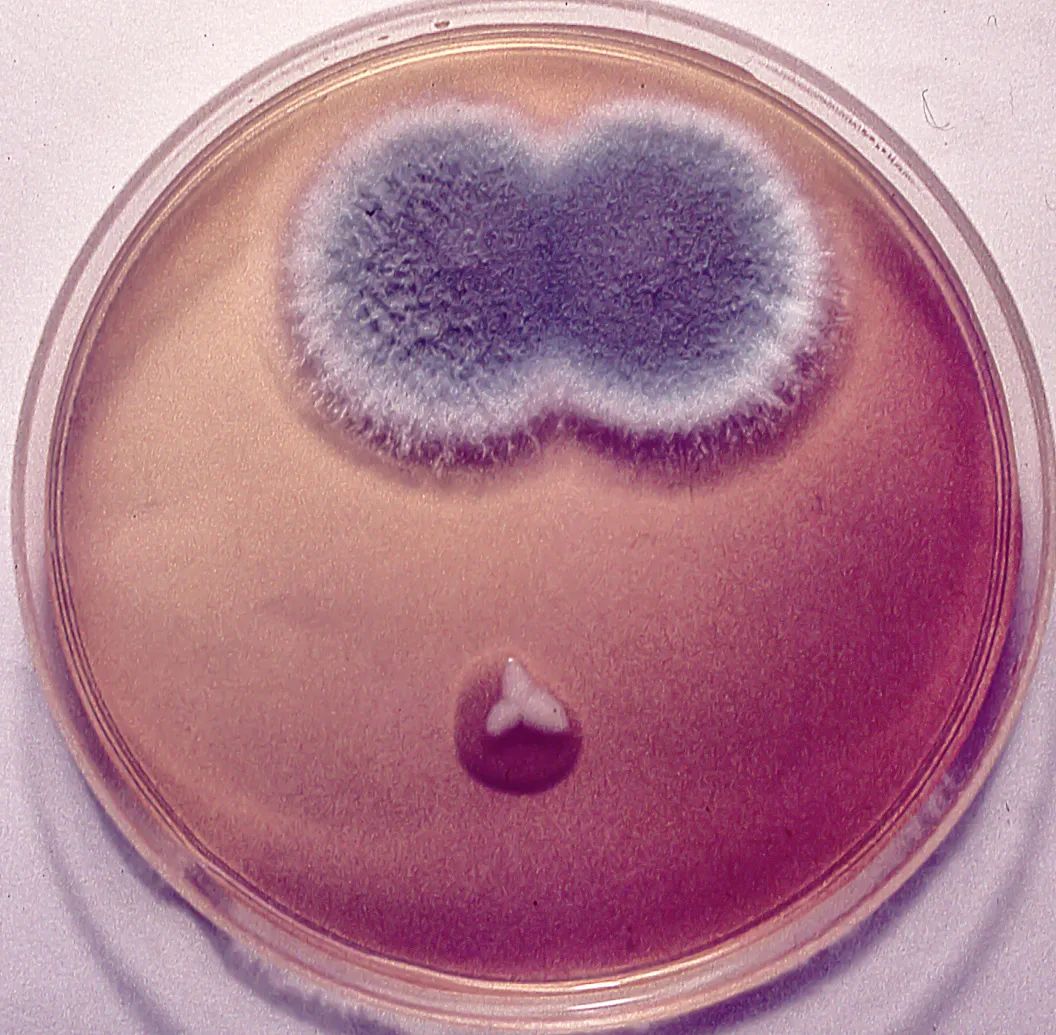

警觉!这些霉菌正悄悄地污染你的食物
原创 宝山疾控 宝山疾控
警觉!这些霉菌
正悄悄地污染你的食物。
我是时间的刺绣师——
用绒毛在遗忘的角落写日记,
用邮戳盖住面包,为草莓披上星图,
将奶酪改造成月光斑驳的地图。 ——霉菌
谁是食物发霉的“罪魁祸首”?

霉菌

常见的霉菌家族:
1青霉菌:面包/水果上的蓝绿色斑点-引起呼吸道感染,过敏症状,毒素污染,引起肾损伤和癌症。
2黄曲霉菌:花生/玉米上的黄色霉菌-1类致癌物,引起急性肝损伤、呕吐、腹痛、昏迷;肝癌、免疫抑制和生长发育迟缓会长期引起。
三赭曲霉菌:谷物/咖啡豆上的褐色霉菌-诱导儿童哮喘,降低免疫力,引起人肺病和肾炎。
四毛霉菌:水果上的白色绒毛-引起鼻塞、面部肿胀(鼻脑型);干咳,咳血(肺型),伤口溃烂,黑色焦痂(皮肤型)。

小常识

一种发霉的食物可能同时存在多种发霉。
耐高温:280℃以上可破坏毒素。
不仅会引起腹泻,还会引起急性中毒(呕吐/肝炎/呼吸不畅)、慢性损伤(肝硬化/肾衰竭)、
为什么食物会发霉?



霉菌最爱三兄弟:
营养:蛋白质/碳水化合物含量高的食物最危险
二是湿度>65%时霉菌狂欢
温度:25-30℃是最佳繁殖温度。
霉菌类型
最佳生长温度
例如危险食品
黄曲霉菌
25-30°C
花生、玉米
青霉菌
20-25℃
面包、柑桔
赫曲霉
25-30°C
咖啡、谷物
毛霉菌
25-30°C
面包、番茄
黑曲霉
30-37°C
坚果、坚果
实战防霉指南

发霉怎么办

防霉三招:
1购买:少买勤买,检查包装的完整性
2储存:低温干燥储存(冰箱)<4℃)、干货加干燥剂,米粉用密封罐
3处理:整个发霉的食物丢失,检查周围的食物,发霉的食物接触到的碗和盒子等。 彻底清洗洗涤剂,用稀释的白醋或酒精擦拭冰箱或储物区进行消毒。

即使发霉部位被切除,也不安全。

紧急提醒专家
误解必须被打破
把发霉的部分切掉还可以吃
煮沸是安全的
没有长毛就没有问题

健康比节约更重要!


图片均来源于摄图网
宝山区科普项目资助(项目编号:2023-1-L001)

供稿 微生物检验科 朱斯远
编辑 蔡柯祎
审稿 张月娟 李琳 宗莲
优选回顾
标题:“警惕!这些霉菌正悄悄地污染你的食物”
阅读原文
本文仅代表作者观点,版权归原创者所有,如需转载请在文中注明来源及作者名字。
免责声明:本文系转载编辑文章,仅作分享之用。如分享内容、图片侵犯到您的版权或非授权发布,请及时与我们联系进行审核处理或删除,您可以发送材料至邮箱:service@tojoy.com








